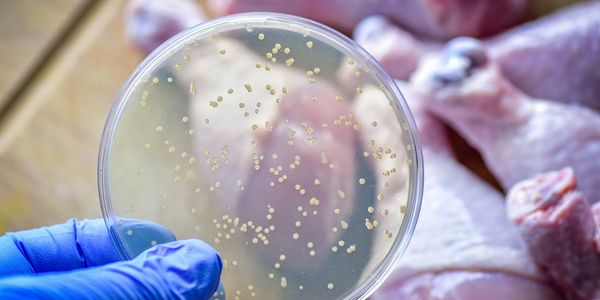

Articles

AI, Sustainability and Health: Top Food Industry Trends in 2026
Artificial intelligence, environmental responsibility, and health-focused innovation are expected to define major food industry developments in 2026. Companies are increasingly deploying AI to improve supply chain visibility, optimize production, and enhance quality control, while sustainability initiatives aim to reduce waste, emissions, and resource consumption. At the same time, growing consumer demand for healthier and more transparent food options is influencing product formulation, labeling, and operational strategy across the sector.

Food Scientists Outline Top Five Trends Shaping Food Policy, Innovation in 2026
Food scientists have identified several emerging trends expected to influence food policy and innovation in 2026. Key themes include strengthened food safety frameworks, evolving regulatory standards, sustainability considerations, advances in food technology, and greater emphasis on transparency across supply chains. Together, these developments reflect ongoing efforts to align scientific research, public health priorities, and industry practices within a rapidly changing global food system.

AI Revolutionizes Food Safety and Quality Control Market, Projected to Grow at a CAGR of 30.9%
According to the latest study from BCC Research, the “AI in Food Safety and Quality Control Market” is projected to reach $13.7 billion by 2030, growing at a CAGR of 30.9% from 2025 to 2030. The report highlights how artificial intelligence is revolutionizing food safety and quality control across the global food value chain. It explores AI technologies like machine learning (ML), computer vision, natural language processing (NLP), and robotics, and their applications in areas such as contaminant detection, traceability, and compliance.

Digitizing Food Safety: Technology's Role in Safer, Smarter Food Production
Today’s safety practices are increasingly enabled by sensors, software and cloud platforms, which not only improves compliance and traceability — it reshapes how the industry thinks about readiness, training and operational excellence.
The role of artificial intelligence in advancing food safety: A strategic path to zero contamination
Food safety is advancing toward zero contamination using artificial intelligence (AI) for supply chain management, quality control, contamination detection, and consumer safety. AI integrates with technologies like the Internet of Things (IoT), blockchain, and genomics to enhance traceability, predictive analytics, and pathogen identification across the food supply chain.

Food safety tech: AI platform helps with product reformulation
SAN FRANCISCO — Turing Labs Inc., a technology startup founded in 2019 by Manmit Shrimali and Ajith Govind, has launched an enhanced version of its artificial intelligence (AI) powered platform. Turing Labs is an AI-powered platform that helps consumer packaged goods (CPG) companies quickly formulate, reformulate and bring products to market faster.

Focus on Food Safety: Using case studies to inform risk assessment methodology
The apple sauce and cinnamon incident in the United States raised many concerns about how risk is approached for safety and integrity. When assessing risk within typical food safety management system, we were trained to the same classic hazards. The vocabulary is changing, and it is important to reflect on the implications of each category.

Food Industry Must Prepare for New Era of Risk Management, Says LRQA
As the Global Food Safety Initiative (GFSI) Conference 2024 takes place in Singapore April 8-11, global assurance partner LRQA is warning that food businesses need to uphold regulatory obligations and meet consumer expectations of safe, authentic, high-quality products and demonstrate integrity across their supply chain.

Driving Restaurant Food Safety with IoT-Enabled Digitalization
Restaurant operators have a critical responsibility to safeguard the health of their customers. Mitigating foodborne illness must be top of mind today more than ever. The potential risks are too severe to overlook, especially with new FSMA 2026 regulations on the horizon.
